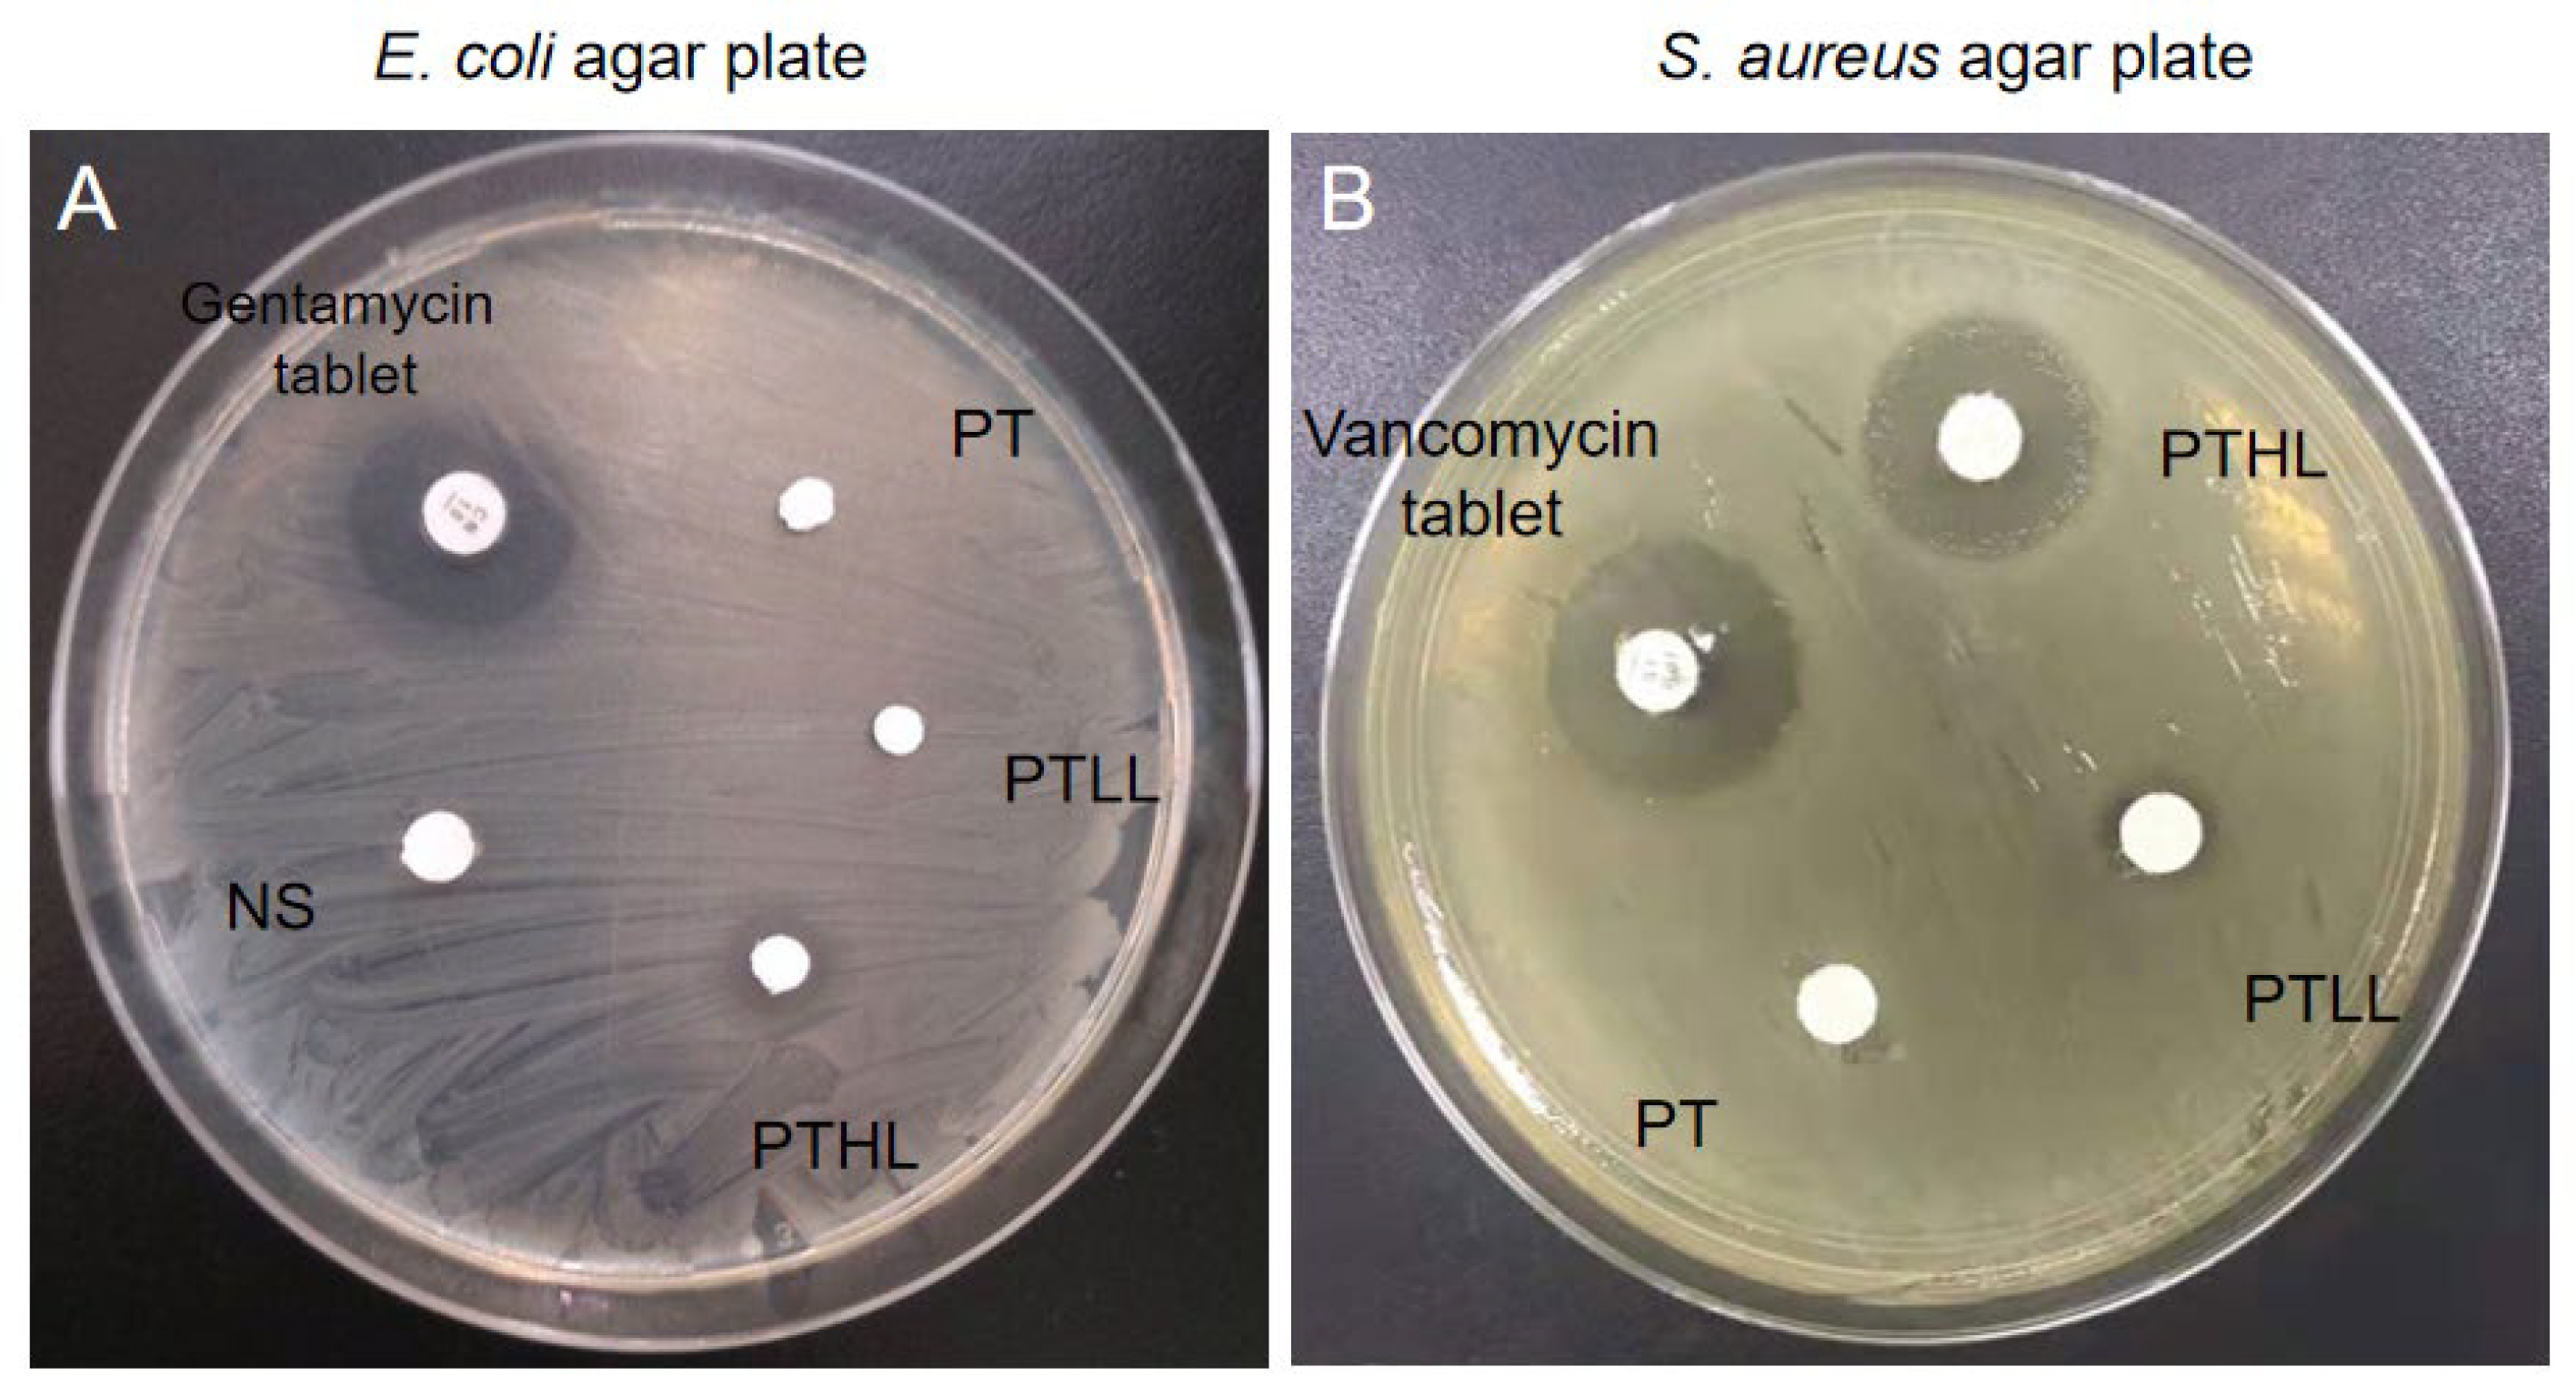

LL-37-Coupled Porous Composite Scaffold for the Treatment of Infected Segmental Bone Defect
Abstract
1. Introduction
2. Materials and Methods
2.1. Chemicals and Reagents
2.2. Preparation of Porous PTL Composite Scaffolds
2.3. The Surface Morphology of Scaffold
2.4. Degradation Assay In Vitro
2.5. Cytotoxicity, Osteo-Promotive Effects and LL-37 Release In Vitro
2.5.1. CCK-8 Cell Proliferation Assay
2.5.2. ALP Active Assay
2.5.3. LL-37 Release In Vitro
2.6. Antimicrobial Activity In Vitro
2.7. Osteo-Promotive Effects of the PTL Scaffolds In Vivo
2.7.1. Micro-CT Analysis of Trabecular Architecture
2.7.2. Histological Evaluation
2.8. Statistical Analysis
3. Results
3.1. Morphology of the PTL Scaffolds
3.2. Biocompatibility, Degradation Rate, Osteo-Inductivity and Controlled Release of the PTL Scaffolds In Vitro
3.3. Antimicrobial Activity In Vitro
3.4. Osteo-Promotive Effects of the PTL Scaffolds In Vivo
3.4.1. Radiography
3.4.2. Histological Analysis
4. Discussion
5. Conclusions
Author Contributions
Funding
Institutional Review Board Statement
Informed Consent Statement
Data Availability Statement
Conflicts of Interest
References
- Zhang, L.; Yang, G.; Johnson, B.N.; Jia, X. Three-dimensional (3D) printed scaffold and material selection for bone repair. Acta Biomater. 2018, 84, 16–33. [Google Scholar] [CrossRef] [PubMed]
- Deluiz, D.; Delcroix, G.J.-R.; D’Ippolito, G.; Grau-Monge, C.; Bonnin-Marquez, A.; Reiner, T.; Tinoco, E.M.B.; Amadeu, T.; Pires, F.R.; Schiller, P.C. Human Bone Marrow-Derived Mesenchymal Stromal Cell-Seeded Bone Biomaterial Directs Fast and Superior Mandibular Bone Augmentation in Rats. Sci. Rep. 2019, 9, 11806. [Google Scholar] [CrossRef] [PubMed]
- Böhmig, G.A.; Eskandary, F.; Doberer, K.; Halloran, P.F. The therapeutic challenge of late antibody-mediated kidney allograft rejection. Transpl. Int. 2019, 32, 775–788. [Google Scholar] [CrossRef] [PubMed]
- Temple, H.T. Allograft Reconstruction of the Knee—Methods and Outcomes. J. Knee Surg. 2019, 32, 315–321. [Google Scholar] [CrossRef] [PubMed]
- Biondi, M.; Ungaro, F.; Quaglia, F.; Netti, P.A. Controlled drug delivery in tissue engineering. Adv. Drug Deliv. Rev. 2008, 60, 229–242. [Google Scholar] [CrossRef] [PubMed]
- Rocha, C.V.; Gonçalves, V.; da Silva, M.C.; Bañobre-López, M.; Gallo, J. PLGA-Based Composites for Various Biomedical Applications. Int. J. Mol. Sci. 2022, 23, 2034. [Google Scholar] [CrossRef] [PubMed]
- Lai, Y.; Cao, H.; Wang, X.; Chen, S.; Zhang, M.; Wang, N.; Yao, Z.; Dai, Y.; Xie, X.; Zhang, P.; et al. Porous composite scaffold incorporating osteogenic phytomolecule icariin for promoting skeletal regeneration in challenging osteonecrotic bone in rabbits. Biomaterials 2018, 153, 1–13. [Google Scholar] [CrossRef]
- Bohner, M.; Santoni, B.; Dobelin, N. beta-tricalcium phosphate for bone substitution: Synthesis and properties. Acta Biomater. 2020, 113, 23–41. [Google Scholar] [CrossRef]
- Lee, S.K.; Han, C.M.; Park, W.; Kim, I.H.; Joung, Y.K.; Han, D.K. Synergistically enhanced osteoconductivity and anti-inflammation of PLGA/beta-TCP/Mg(OH)2 composite for orthopedic applications. Mater. Sci. Eng. C Mater. Biol. Appl. 2019, 94, 65–75. [Google Scholar] [CrossRef]
- Dos Santos, V.I.; Merlini, C.; Aragones, Á.; Cesca, K.; Fredel, M.C. In vitro evaluation of bilayer membranes of PLGA/hydroxyapatite/beta-tricalcium phosphate for guided bone regeneration. Mater. Sci. Eng. C Mater. Biol. Appl. 2020, 112, 110849. [Google Scholar] [CrossRef]
- Lai, Y.; Li, Y.; Cao, H.; Long, J.; Wang, X.; Li, L.; Li, C.; Jia, Q.; Teng, B.; Tang, T.; et al. Osteogenic magnesium incorporated into PLGA/TCP porous scaffold by 3D printing for repairing challenging bone defect. Biomaterials 2019, 197, 207–219. [Google Scholar] [CrossRef]
- Johnson, C.; García, A.J. Scaffold-based Anti-infection Strategies in Bone Repair. Ann. Biomed. Eng. 2015, 43, 515–528. [Google Scholar] [CrossRef]
- Darouiche, R.O. Treatment of Infections Associated with Surgical Implants. N. Engl. J. Med. 2004, 350, 1422–1429. [Google Scholar] [CrossRef]
- Yang, Y.; Chu, L.; Yang, S.; Zhang, H.; Qin, L.; Guillaume, O.; Tang, T. Dual-functional 3D-printed composite scaffold for inhibiting bacterial infection and promoting bone regener-ation in infected bone defect models. Acta. Biomater. 2018, 79, 265–275. [Google Scholar] [CrossRef]
- Cobb, L.H.; McCabe, E.M.; Priddy, L.B. Therapeutics and delivery vehicles for local treatment of osteomyelitis. J. Orthop. Res. 2020, 38, 2091–2103. [Google Scholar] [CrossRef]
- Bezstarosti, H.; Metsemakers, W.J.; van Lieshout, E.M.M.; Voskamp, L.W.; Kortram, K.; McNally, M.A.; Marais, L.C.; Verhofstad, M.H.J. Management of critical-sized bone defects in the treatment of fracture-related infection: A systematic review and pooled analysis. Arch. Orthop. Trauma Surg. 2021, 141, 1215–1230. [Google Scholar] [CrossRef]
- Zhao, C.; Liu, W.; Zhu, M.; Wu, C.; Zhu, Y. Bioceramic-based scaffolds with antibacterial function for bone tissue engineering: A review. Bioact. Mater. 2022, 18, 383–398. [Google Scholar] [CrossRef]
- Vincent, M.; Duval, R.E.; Hartemann, P.; Engels-Deutsch, M. Contact killing and antimicrobial properties of copper. J. Appl. Microbiol. 2018, 124, 1032–1046. [Google Scholar] [CrossRef]
- Aničić, N.; Kurtjak, M.; Jeverica, S.; Suvorov, D.; Vukomanović, M. Antimicrobial Polymeric Composites with Embedded Nano-textured Magnesium Oxide. Polymers 2021, 13, 2183. [Google Scholar] [CrossRef]
- Lai, Y.P.; Gallo, R.L. AMPed up immunity: How antimicrobial peptides have multiple roles in immune defense. Trends Immunol. 2009, 30, 131–141. [Google Scholar] [CrossRef]
- Pahar, B.; Madonna, S.; Das, A.; Albanesi, C.; Girolomoni, G. Immunomodulatory Role of the Antimicrobial LL-37 Peptide in Autoimmune Diseases and Viral Infections. Vaccines 2020, 8, 517. [Google Scholar] [CrossRef] [PubMed]
- Zhu, C.; Wang, J.; Cheng, T.; Li, Q.; Shen, H.; Qin, H.; Zhang, X. The potential role of increasing the release of mouse beta- defensin-14 in the treatment of osteomyelitis in mice: A primary study. PLoS ONE 2014, 9, e86874. [Google Scholar]
- Zhu, C.; Bao, N.R.; Chen, S.; Zhao, J.N. The mechanism of human beta-defensin 3 in MRSA-induced infection of implant drug-resistant bacteria biofilm in the mouse tibial bone marrow. Exp. Ther. Med. 2017, 13, 1347–1352. [Google Scholar] [CrossRef] [PubMed][Green Version]
- Hao, Z.; Chen, R.; Chai, C.; Wang, Y.; Chen, T.; Li, H.; Hu, Y.; Feng, Q.; Li, J. Antimicrobial peptides for bone tissue engineering: Diversity, effects and applications. Front. Bioeng. Biotechnol. 2022, 10, 1030162. [Google Scholar] [CrossRef] [PubMed]
- Luo, Y.; Song, Y. Mechanism of Antimicrobial Peptides: Antimicrobial, Anti-Inflammatory and Antibiofilm Activities. Int. J. Mol. Sci. 2021, 22, 11401. [Google Scholar] [CrossRef]
- Nagaoka, I.; Tamura, H.; Reich, J. Therapeutic Potential of Cathelicidin Peptide LL-37, an Antimicrobial Agent, in a Murine Sepsis Model. Int. J. Mol. Sci. 2020, 21, 5973. [Google Scholar] [CrossRef]
- Mai, S.; Mauger, M.T.; Niu, L.-N.; Barnes, J.B.; Kao, S.; Bergeron, B.E.; Ling, J.-Q.; Tay, F.R. Potential applications of antimicrobial peptides and their mimics in combating caries and pulpal infections. Acta Biomater. 2017, 49, 16–35. [Google Scholar] [CrossRef]
- Moreno-Angarita, A.; Aragón, C.C.; Tobón, G.J. Cathelicidin LL-37: A new important molecule in the pathophysiology of systemic lupus erythematosus. J. Transl. Autoimmun. 2020, 3, 100029. [Google Scholar] [CrossRef]
- Engelberg, Y.; Landau, M. The Human LL-37(17-29) antimicrobial peptide reveals a functional supramolecular structure. Nat. Commun. 2020, 11, 3894. [Google Scholar] [CrossRef]
- Ridyard, K.E.; Overhage, J. The Potential of Human Peptide LL-37 as an Antimicrobial and Anti-Biofilm Agent. Antibiotics 2021, 10, 650. [Google Scholar] [CrossRef]
- Lande, R.; Botti, E.; Jandus, C.; Dojcinovic, D.; Fanelli, G.; Conrad, C.; Chamilos, G.; Feldmeyer, L.; Marinari, B.; Chon, S.; et al. The antimicrobial peptide LL37 is a T-cell autoantigen in psoriasis. Nat. Commun. 2014, 5, 5621. [Google Scholar] [CrossRef]
- Yu, X.; Quan, J.; Long, W.; Chen, H.; Wang, R.; Guo, J.; Lin, X.; Mai, S. LL-37 inhibits LPS-induced inflammation and stimulates the osteogenic differentiation of BMSCs via P2X7 receptor and MAPK signaling pathway. Exp. Cell Res. 2018, 372, 178–187. [Google Scholar] [CrossRef]
- Friberg, C.; Haaber, J.K.; Vestergaard, M.; Fait, A.; Perrot, V.; Levin, B.R.; Ingmer, H. Human antimicrobial peptide, LL-37, induces non-inheritable reduced susceptibility to vancomycin in Staphylococcus aureus. Sci. Rep. 2020, 10, 13121. [Google Scholar] [CrossRef]
- Chinipardaz, Z.; Zhong, J.M.; Yang, S. Regulation of LL-37 in Bone and Periodontium Regeneration. Life 2022, 12, 1533. [Google Scholar] [CrossRef]
- Qin, L.; He, T.; Yang, D.; Wang, Y.; Li, Z.; Yan, Q.; Zhang, P.; Chen, Z.; Lin, S.; Gao, H.; et al. Osteocyte β1 integrin loss causes low bone mass and impairs bone mechanotransduction in mice. J. Orthop. Transl. 2022, 17, 60–72. [Google Scholar] [CrossRef]
- Yan, C.; Liu, Y.; Xu, Z.; Yang, H.; Li, J. Comparison of Antibacterial Effect of Cationic PeptideLL-37 and Cefalexin on Clinical Staphylococcus aureus-induced Infection after Femur Fracture Fixation. Orthop. Surg. 2020, 12, 1313–1318. [Google Scholar] [CrossRef]
- Shen, X.; Al Baadani, M.A.; He, H.; Cai, L.; Wu, Z.; Yao, L.; Wu, X.; Wu, S.; Chen, M.; Zhang, H.; et al. Antibacterial and osteogenesis performances of LL37-loaded titania nanopores in vitro and in vivo. Int. J. Nanomed. 2019, 14, 3043–3054. [Google Scholar] [CrossRef]
- Li, L.; Peng, Y.; Yuan, Q.; Sun, J.; Zhuang, A.; Bi, X. Cathelicidin LL37 Promotes Osteogenic Differentiation in vitro and Bone Re-generation in vivo. Front. Bioeng. Biotechnol. 2021, 9, 638494. [Google Scholar] [CrossRef]
- Kondiah, P.J.; Kondiah, P.P.D.; Choonara, Y.E.; Marimuthu, T.; Pillay, V. A 3D Bioprinted Pseudo-Bone Drug Delivery Scaffold for Bone Tissue Engineering. Pharmaceutics 2020, 12, 166. [Google Scholar] [CrossRef]

Disclaimer/Publisher’s Note: The statements, opinions and data contained in all publications are solely those of the individual author(s) and contributor(s) and not of MDPI and/or the editor(s). MDPI and/or the editor(s) disclaim responsibility for any injury to people or property resulting from any ideas, methods, instructions or products referred to in the content. |
© 2022 by the authors. Licensee MDPI, Basel, Switzerland. This article is an open access article distributed under the terms and conditions of the Creative Commons Attribution (CC BY) license (https://creativecommons.org/licenses/by/4.0/).
Share and Cite
Li, X.; Huang, X.; Li, L.; Wu, J.; Yi, W.; Lai, Y.; Qin, L. LL-37-Coupled Porous Composite Scaffold for the Treatment of Infected Segmental Bone Defect. Pharmaceutics 2023, 15, 88. https://doi.org/10.3390/pharmaceutics15010088
Li X, Huang X, Li L, Wu J, Yi W, Lai Y, Qin L. LL-37-Coupled Porous Composite Scaffold for the Treatment of Infected Segmental Bone Defect. Pharmaceutics. 2023; 15(1):88. https://doi.org/10.3390/pharmaceutics15010088
Chicago/Turabian StyleLi, Xialin, Xingyu Huang, Long Li, Jiayi Wu, Weihong Yi, Yuxiao Lai, and Lei Qin. 2023. "LL-37-Coupled Porous Composite Scaffold for the Treatment of Infected Segmental Bone Defect" Pharmaceutics 15, no. 1: 88. https://doi.org/10.3390/pharmaceutics15010088
APA StyleLi, X., Huang, X., Li, L., Wu, J., Yi, W., Lai, Y., & Qin, L. (2023). LL-37-Coupled Porous Composite Scaffold for the Treatment of Infected Segmental Bone Defect. Pharmaceutics, 15(1), 88. https://doi.org/10.3390/pharmaceutics15010088
